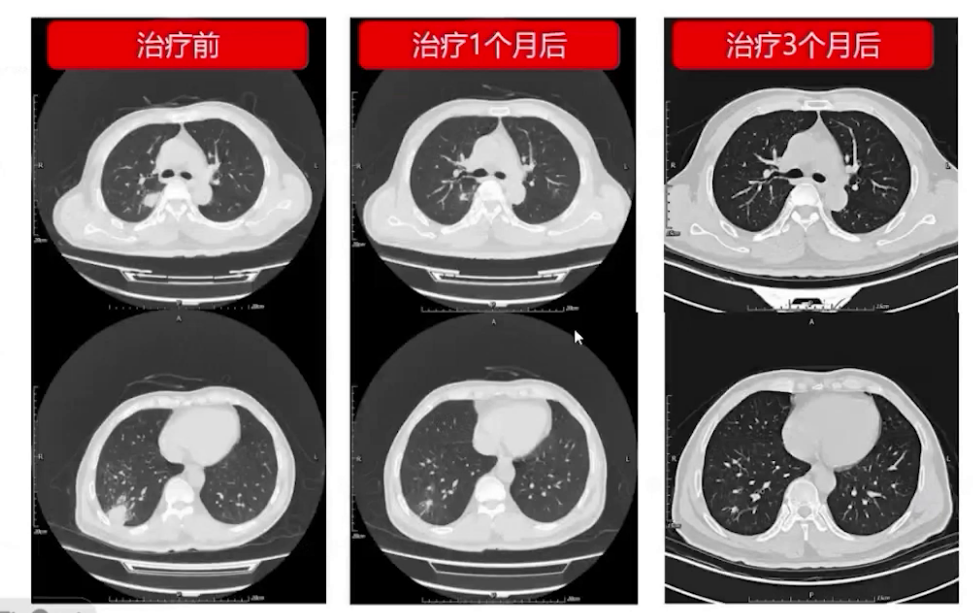
图片 26.png

查看更多
密码过期或已经不安全,请修改密码
修改密码
壹生身份认证协议书
同意
拒绝
同意
拒绝
同意
不同意并跳过
53岁中年男性,主诉间断发热、咳痰1月余,右侧肢体活动障碍1月。
患者入院1月余前无明显诱因出现发热,体温最高39.0℃,伴有咳嗽、咳痰,每日约十几口痰,偶有痰中带血丝,无胸痛、胸闷、气短、头痛等不适,自诉自测新冠抗原阳性。2023-7-18胸部CT可见双下肺微小结节影,服用先诺特韦/利托那韦片5天治疗,仍间断发热,伴有咳褐色样黏痰。2023-7-26复查胸部CT可见双肺多发结节、斑片状影,右下肺可见空洞样病变,周围晕征明显。2023-7-26晚间患者无诱因出现右侧肢体活动障碍,走路不协调、无法持筷、言语不流畅,无晕厥、头痛、意识障碍、二便失禁、呛咳、肢体麻木等不适。当日患者就诊于北京某院,血常规提示白细胞36.59×10⁹/L,咽拭子示新冠核酸检测阳性,四肢血管超声无异常,头CT:左枕叶、左侧脑室旁、左侧额顶叶多发低密度影,结合病史考虑转移灶,其中左枕叶伴出血可能,双侧额窦、上颌窦及右侧蝶窦炎可能。诊断考虑急性白血病伴脑转移,经抗病毒、抗真菌等对症治疗后症状无明显改善,遂转入本科室。
既往高血压13年,血压最高160/100mmHg,口服“硝苯地平缓释片Ⅱ 1片/日”,血压控制可;“慢性淋巴细胞白血病”病史2年,家属诉外院定期随访、评估病情稳定,长期口服“伊布替尼”治疗(2023-7-28因抗病毒药物联用禁忌已停药)。
入院查体生命体征正常,双下肺呼吸音低,右侧肌力Ⅲ级。
实验室检查
白细胞14×10⁹/L,中性粒细胞、CRP、血沉、转氨酶、甘油三酯、乳酸脱氢酶轻度升高;感染指标PCT及G试验阴性,GM试验阳性,曲霉菌抗体及半乳甘露聚糖阳性,痰培养发现个别烟曲霉。
影像学检查
胸部CT显示双肺多发结节、斑片状影,右下肺空洞样病变较前实变;头颅增强MRI提示左侧额叶脑室多发脓肿病灶且脓肿壁强化;浅表淋巴结超声提示腹股沟和腋窝多发肿大淋巴结。




初步诊断
1、肺部阴影待查;2、颅脑占位待查;3、慢性淋巴细胞白血病;4、高血压病3级极高危组。
诊疗经过
入院后先给予氟康唑及舒普深抗感染治疗,感染指标趋于正常。


完善支气管镜检查,发现双侧主支气管壁有灰白色物质黏附,管壁充血水肿,肺泡灌洗液NGS检查回报合并诺卡菌、烟曲霉、黄曲霉及新冠病毒感染,BALF液GM试验阳性且免疫荧光检查见曲霉菌菌丝及分生孢子。



腰椎穿刺及脑脊液检查无异常。

多学科MDT讨论
神经外科建议脑脓肿钻孔引流术;耳鼻喉科建议真菌性鼻窦炎手术根治;血液科认为慢性粒细胞白血病病情稳定,以抗感染治疗为主。
患者转入神经外科行脑脓肿钻孔引流及活检术,脑脓肿液NGS回报构巢曲霉;耳鼻喉科行鼻窦开放及窦内病变去除术,组织病理显示右侧上颌窦及蝶窦符合曲霉菌病理改变。


最终诊断
1、急性侵袭性肺曲霉病;2、多发脑脓肿、颅内曲霉菌感染;3、真菌性蝶窦炎;4、真菌性上颌窦炎;5、慢性粒细胞白血病;6、高血压病 3级极高危。
后续治疗及随访
给予伏立康唑片200mg bid抗真菌治疗。
患者出院后症状改善,右侧肢体肌力恢复正常,定期监测伏立康唑血药浓度正常,随访胸部CT及头颅MRI显示病灶持续缩小。
查看更多
专家点评
该患者以发热起病,初期疑诊新型冠状病毒感染,规范治疗一周后病情无改善,继发肢体活动障碍、意识改变,肺部影像学快速进展且出现颅内多发占位性病变。入院24小时内完成脑脊液及肺泡灌洗液病原学检测,明确诊断后启动目标治疗,经多学科联合会诊,采取内科治疗联合外科手术清除颅内及鼻窦扩散病灶的方案,最终取得良好治疗效果。
侵袭性曲霉病的早期诊断与及时干预是改善患者临床预后的核心,需当机立断开展针对性治疗,多学科诊疗模式可有效提升治疗效果。唑类药物为曲霉菌感染首选治疗药物,但全球范围内其耐药性急剧上升,我国烟曲霉耐唑分离株比例已达 5.6%,临床需同步监测血药浓度与药敏情况,制定个体化治疗策略。
随着mNGS技术的应用,多重病原同时检出的情况日益常见。如本例患者肺泡灌洗mNGS结果同时检出新冠病毒、诺卡菌及曲霉菌,而诺卡菌也易引发多部位播散。临床需注意甄别定植病原与致病原,实施精准治疗,避免盲目广谱或全覆盖治疗,以减少药物相关并发症、不良反应,同时减轻患者经济负担。